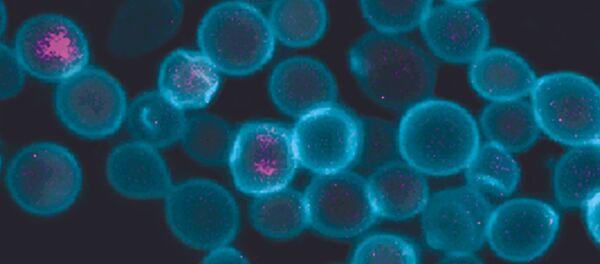
Células de leveduras com mitocôndrias produzidas artificialmente - Sputnik Brasil

Relata-se que a descoberta foi realizada na área da necrópole, local onde se enterrava os nômades que vieram para o sul do Egito há mais de três mil anos.
A mulher, que tinha cerca de 25 anos no momento em que morreu, estava no último período de gestação.
Foi indicado que a possível causa da morte teria sido por complicações no parto – uma lesão mal curada nos ossos pélvicos poderia ter provocado o falecimento.
Cestas, pérolas brutas e vasos de barro foram encontrados no túmulo, o que, segundo os arqueólogos, sugere que a mulher se dedicava à criação de joias.